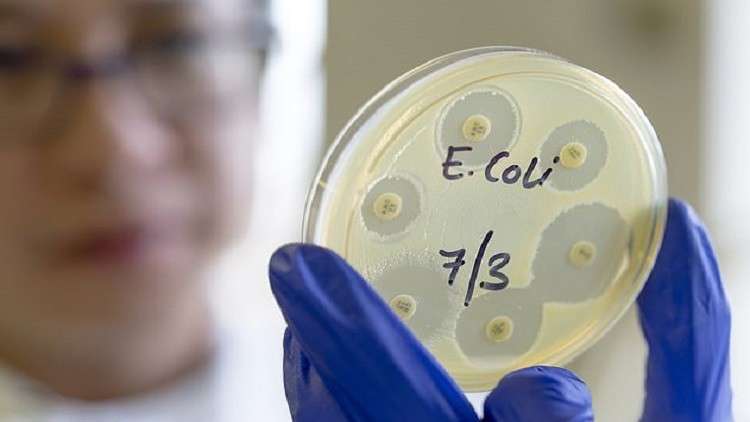
ابتكار أول

Stories
-
العملية العسكرية الروسية في أوكرانيا
RT STORIES
خبير يتحدث عما هو أسوأ بكثير من انقطاع الكهرباء قد يصيب كييف ومدنا أوكرانية
#اسأل_أكثر #Question_MoreRT STORIES
الدفاع الجوي يدمر 146 مسيرة معادية فوق مناطق روسيا خلال 6 ساعات
#اسأل_أكثر #Question_MoreRT STORIES
موقع بوليتيكو يحدد سببا حاسما وراء تراجع اهتمام ترامب بالتسوية في أوكرانيا
#اسأل_أكثر #Question_MoreRT STORIES
"بوليتيكو": زيلينسكي يعمل على استراتيجية لإجراء المفاوضات مع روسيا دون مساعدة الولايات المتحدة
#اسأل_أكثر #Question_MoreRT STORIES
الجيش الروسي يسيطر على بلدة في سومي
#اسأل_أكثر #Question_MoreRT STORIES
مقاطعة خاركوف.. لقطات لمعارك تحرير بلدة بوكاليانوي
#اسأل_أكثر #Question_MoreRT STORIES
على خلفية الخسائر الضخمة وفرار الجنود زيلينسكي يغري المشاة بزيادة رواتبهم
#اسأل_أكثر #Question_MoreRT STORIES
الدفاع الروسية: تدمير 100 مسيرة أوكرانية فوق مناطق روسية وبحر آزوف خلال 9 ساعات
#اسأل_أكثر #Question_MoreRT STORIES
"تاس": تصدير المنتجات العسكرية من صربيا والبوسنة والهرسك إلى أوكرانيا مستمر
#اسأل_أكثر #Question_More
العملية العسكرية الروسية في أوكرانيا
-
إسرائيل تواصل غاراتها على لبنان
RT STORIES
لبنان.. اجتماع "استثنائي" بين قائد الجيش ورئيس لجنة "الميكانيزم"
#اسأل_أكثر #Question_MoreRT STORIES
الجيش الإسرائيلي: استهدفنا نحو 120 هدفا في جنوب لبنان خلال نهاية الأسبوع (صور + فيديو)
#اسأل_أكثر #Question_MoreRT STORIES
"حزب الله" يستهدف تجمعات لجنود إسرائيليين في القنطرة والبياضة
#اسأل_أكثر #Question_MoreRT STORIES
50 غارة في 24 ساعة.. مراسلتنا: قتلى وجرحى بغارات إسرائيلية جنوب لبنان
#اسأل_أكثر #Question_MoreRT STORIES
لحظة بلحظة.. القوات الإسرائيلية تواصل عملياتها جنوب لبنان وحزب الله يرد بالصواريخ والمسيرات
#اسأل_أكثر #Question_MoreRT STORIES
الجيش الإسرائيلي يتهم حزب الله بخرق وقف النار وينذر سكان 9 قرى جنوب لبنان للإخلاء
#اسأل_أكثر #Question_MoreRT STORIES
حزب الله ينشر تفاصيل عملياته العسكرية ضد القوات الإسرائيلية في جنوب لبنان
#اسأل_أكثر #Question_MoreRT STORIES
قناة لبنانية: الرئيس عون لن يذهب للقاء نتنياهو ما دام جزء من الجنوب محتلا والحرب فيه قائمة
#اسأل_أكثر #Question_MoreRT STORIES
القوات الإسرائيلية تجرّف دير ومدرسة راهبات المخلصيات في بلدة يارون جنوب لبنان (فيديو)
#اسأل_أكثر #Question_MoreRT STORIES
إسرائيل تشدد إجراءات الجبهة الداخلية في الشمال وتقلص احتفالات "لاغ باعومر" في ميرون
#اسأل_أكثر #Question_More
إسرائيل تواصل غاراتها على لبنان
-
هدنة وحصار المضيق
RT STORIES
"قناة 12" عن مصادر: إسرائيل تستعد لاحتمال شن الولايات المتحدة هجوما قريبا على إيران
#اسأل_أكثر #Question_MoreRT STORIES
وزير العدل الإيراني: العدو يسعى إلى زرع الفتنة وإحداث انقسام داخل البلاد بعد فشله في الميدان
#اسأل_أكثر #Question_MoreRT STORIES
الصين.. وزارة التجارة تمنع تطبيق العقوبات الأمريكية على 5 مصافي بترول
#اسأل_أكثر #Question_MoreRT STORIES
رد فعل "مفاجىء وبارد" لبيستوريوس على قرار ترامب سحب آلاف الجنود الأمريكيين من ألمانيا
#اسأل_أكثر #Question_MoreRT STORIES
مسؤول إيراني يكشف فحوى مقترح طهران الذي رفضه ترامب
#اسأل_أكثر #Question_MoreRT STORIES
لحظة بلحظة.. ضغط متبادل بين واشنطن وطهران في ظل استمرار "إغلاق وحصار هرمز"
#اسأل_أكثر #Question_MoreRT STORIES
"وول ستريت جورنال": المسيرات الإيرانية "الرخيصة" أثبتت فعاليتها أمام منظومات "ثاد" الأمريكية
#اسأل_أكثر #Question_MoreRT STORIES
ترامب: قادة إيران "اختفوا" وليس هناك من يمكن التعامل معه (فيديو)
#اسأل_أكثر #Question_MoreRT STORIES
"مثل عش النمل".. ترامب يشرح كيف تطبق واشنطن الحصار البحري على إيران (فيديو)
#اسأل_أكثر #Question_MoreRT STORIES
الحرس الثوري الإيراني يعلن فرض "قواعد جديدة" لإدارة الخليج ومضيق هرمز
#اسأل_أكثر #Question_MoreRT STORIES
"أسوشيتد برس": البيت الأبيض يبلغ الكونغرس بأنه يعتبر العملية ضد إيران منتهية
#اسأل_أكثر #Question_MoreRT STORIES
عراقجي ولافروف يبحثان موقف إيران من انهاء الصراع مع الولايات المتحدة وإسرائيل ووضع منطقة الخليج
#اسأل_أكثر #Question_More
هدنة وحصار المضيق
-
نبض الملاعب
RT STORIES
ماذا لو فازت إيران بكأس العالم في الولايات المتحدة؟.. ترامب يعلق
#اسأل_أكثر #Question_MoreRT STORIES
أول تعليق من صلاح حول وجهته المقبلة بعد إعلان رحيله عن ليفربول
#اسأل_أكثر #Question_MoreRT STORIES
سيدات روسيا للسباحة الإيقاعية يتوجن بذهبية البرنامج الحر في كأس العالم
#اسأل_أكثر #Question_MoreRT STORIES
أول تعليق من مدرب الأهلي بعد فوز فريقه على الزمالك بثلاثية
#اسأل_أكثر #Question_MoreRT STORIES
إصابة جديدة.. نجم ريال مدريد مهدد بالغياب عن مباراة الكلاسيكو
#اسأل_أكثر #Question_MoreRT STORIES
وفاة سائق فورمولا 1 السابق وبطل الألعاب البارالمبية زاناردي عن عمر 59 عاما
#اسأل_أكثر #Question_MoreRT STORIES
وداع يليق بأسطورة.. نجوم كرة القدم يودعون محمد صلاح برسائل مؤثرة (فيديو)
#اسأل_أكثر #Question_MoreRT STORIES
ماذا يعني احتفال كريستيانو رونالدو بحركته الأيقونية "Siuu".. الدون يكشف كواليس هذا الاحتفال ؟
#اسأل_أكثر #Question_MoreRT STORIES
رئيس الاتحاد الإيراني يثير الجدل مجددا حول المشاركة في كأس العالم (فيديو)
#اسأل_أكثر #Question_MoreRT STORIES
محمد صلاح يزف خبرا سارا لجماهير ليفربول (فيديو)
#اسأل_أكثر #Question_MoreRT STORIES
بعد الخسارة الكارثية أمام الأهلي.. الزمالك يتخذ قرارا عاجلا (فيديو)
#اسأل_أكثر #Question_More
نبض الملاعب
-
فيديوهات
RT STORIES
شركة DEEP Robotics تعرض روبوتها الجديد
#اسأل_أكثر #Question_MoreRT STORIES
البرازيل.. فيضانات مدمرة تسفر عن قتلى ومصابين في ولاية "بيرنامبوكو"
#اسأل_أكثر #Question_MoreRT STORIES
قاعدة بايكونور.. نجاح أول إطلاق تجريبي للصاروخ "سويوز-5"
#اسأل_أكثر #Question_MoreRT STORIES
القدس.. لقطات توثق اعتداء مستوطن إسرائيلي على راهبة مسيحية
#اسأل_أكثر #Question_Moreفيديوهات
-
"في جلسة عشاء".. محمد صلاح يكشف عن الشخص الذي أقنعه بمغادرة ليفربول (فيديو)
RT STORIES
"في جلسة عشاء".. محمد صلاح يكشف عن الشخص الذي أقنعه بمغادرة ليفربول (فيديو)
#اسأل_أكثر #Question_More
علماء روس يبتكرون دواء فريدا!
أعلنت وزارة الصحة الروسية عن ابتكار العلماء الروس دواء فريدا يمكن أن يحدث طفرة في علاج أمراض المناعة الذاتية وخاصة التهاب المفاصل والتهاب المفاصل الصدفي.
وأكدت وزارة الصحة أن المرحلة الأولى للتجارب السريرية ستجري في خريف 2019.
ووفقا لوزيرة الصحة الروسية، فيرونيكا سكفورتسوفا، فإن العقار الجديد لا يوجد له نظير في العالم، ويهدف لعلاج التهاب الفقرات التصلبي والتهاب المفاصل الصدفي.
ابتكار أول "دواء حي"!
وأضافت سكفورتسوفا أنه إذا تم تأكيد فعالية الدواء الجديد، فسيكون إنجازا عالميا في مجال الطب.
وأشارت الطبيبة الروسية، إلى أن خصوصية هذا الدواء هي أنه يؤثر على الخلايا التالفة في الجهاز المناعي فقط، دون التأثير على الحالة العامة.
ويقوم هذا الدواء، على عكس نظرائه من العقاقير، بمعالجة أسباب الأمراض وليس آثارها. كما أنه لا يتسبب في "الإدمان" لدى انتفاء الحاجة.
وأظهرت نتائج التجارب، قبل السريرية، المخبرية على القردة والحيوانات الصغيرة الأخرى نجاحا كبيرا. وإذا نجحت التجارب السريرية سيتم الإعلان عن موعد إنتاج العقار.
المصدر: لايف. رو
التعليقات